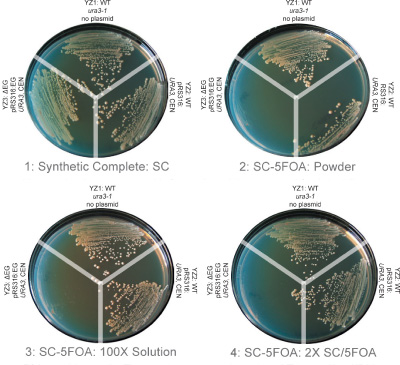

【温馨提示】:见我司懋康生物整理的酵母双杂交检测(Yeast two-hybrid assay)产品专题。
基本描述
5-氟乳清酸(5-Fluoroorotic Acid,5-FOA)用于酵母反选是一种常用的分子遗传筛选方法。酵母菌质粒清除、质粒穿梭、等位置换和双杂交筛选都会用到5-FOA。5-FOA自身对酵母细胞无毒,但功能型URA3基因能编码表达乳清酸核苷-5′-单磷酸脱羧酶(OMP脱羧酶),将其转化为有毒形式(如5-氟尿嘧啶),从而使得酵母细胞无法生长。筛选之后,表型Ura+的酵母菌变为Ura-和5-FOA(R)的酵母菌。
产品应用:
1)检测酵母URA3基因表达;
2)构建酵母双杂交文库;
3)其他酵母遗传学领域包括基因替换,可移动遗传因子分析和基因突变鉴定研究。
筛选对象:
Saccharomyces cerevisiae, Schizosaccharomyces pombe, and other fungi species containing URA3 orthologs.
产品特性:
1)供货形式:化学合成的5-FOA一水合物粉末或液体
2)保存方法:-20ºC
3)分子式:C5H3FN2O4• H2O
4)分子量:174.0
5)纯度:≥ 98%
产品应用:
Fig 1. Counter selection of yeast using 5-FOA.Yeast strains that are auxotrophic for uracil (ura3-1) were tested for their ability to grow on 5-FOA containing media. Three strains were tested: wt alone (YZ1), wt with a URA3 marked low copy plasmid (YZ2), and a mutant strain with a deletion of an essential gene (△EG) that could not lose a complementing URA3 plasmid (YZ3).
From left to right, top to bottom are synthetic complete glucose medium (SC): 1. SC, synthetic complete no 5FOA; 2. Standard - SC-5-FOA (SC-5-FOA made from ultra-pure 5-FOA powder, 1 g/liter) 3. SC-5-FOA made from 100X 5-FOA solution; 4: SC-5-FOA made from 2X SC/5-FOA.
For each plate, Top: Yeast strain: YZ1 wild-type, Ura- (wt, ura-3-52), Right: Yeast strain: YZ2, wt carrying a low copy, URA3 plasmid alone, and Left: Yeast strain: YZ3:△EG, containing the complementing plasmid (pRS316: EG, URA3, CEN). The counter selection against strain YZ3 was evident for all media containing 5-FOA with no 5-FOAR colonies evident (see left panels, YZ3: in plates 2, 3, and 4). Cells from control strains YZ1 and YZ2 were able to grow on 5-FOA media.
产品订购:Zymo Research原装进口,现货供应,欢迎来电咨询021-54736159,QQ:2971634497。由于5-FOA水溶性较差,操作起来比较麻烦,还另提供DMSO储存液(100 x)。
|
货号 |
名称 |
规格 |
价格(元) |
|
F9001-1 |
5-Fluoroorotic Acid (powder) |
1g |
咨询 |
|
F9001-5 |
5-Fluoroorotic Acid (powder) |
5g |
咨询 |
|
F9003 |
100X 5-Fluoroorotic Acid (liquid) |
10ml |
咨询 |
F9001 5-Fluoroorotic Acid Datasheet
另提供进口分装的5-FOA,性价比更高,现货供应,欢迎咨询021-54736159,QQ:2971634497。
|
货号 |
名称 |
规格 |
价格(元) |
|
1g |
386 |
||
|
5g |
1386 |
||
|
500mg |
316 |
||
|
1g |
556 |
注意事项:
1)为了您的安全和健康,请穿实验服并戴一次性手套操作。
2)本品仅用作科研用途,不能用作诊断和药物。
— —Written/Edited by V. Shallan【版权归MKBio懋康所有】
上海懋康生物科技有限公司是一家涉足于生命科学和生物技术领域研究的试剂、仪器和实验室消耗品与实验服务工作,主要从事细胞生物学、植物学、分子生物学、免疫学、生物化学、蛋白组学。生物制药与诊断试剂研发生产等领域。 本公司秉承“以人为本,以诚为信、合同守信”的经营理念。坚持"品质保障"的原则为广大客户提供优质产品。